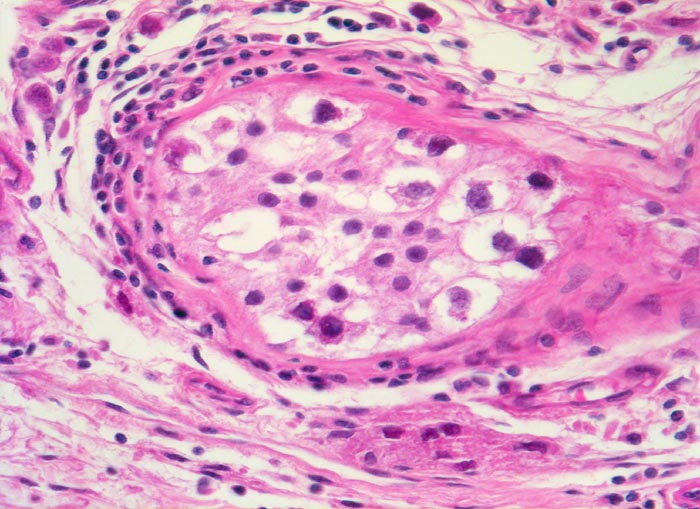

PathoPic – image database / PathoPic ID 4680 - Seminom des Hodens: testikuläre intraepitheliale Neoplasie (TIN)
de
Diagnose
Seminom des Hodens: testikuläre intraepitheliale Neoplasie (TIN)
Diagnose Gruppe
maligner Tumor
Topographie
Hoden
Topographie Gruppe
Genitalorgane, männlich
Beschreibung
Zusatzbefund
Makroskopisch aus mehreren Knoten bestehender weisser Tumor von 2cm Durchmesser.
Klinik
Der Patient suchte den Arzt wegen einer schmerzlosen Hodenvergrösserung auf.
Kommentar
Eine intratubulär wachsende in situ Komponente, die sogenannte testikuläre intraepitheliale Neoplasie (TIN), findet sich sehr oft in der Umgebung von Keimzelltumoren. Obwohl die TIN als obligate Präkanzerose der testikulären Keimzelltumoren gilt, die bereits viele Jahre vor der klinischen Tumormanifestation im Hoden vorhanden ist, gibt es bisher keine Antwort auf die Frage, ob in jedem Falle und wann bei Vorliegen einer TIN tatsächlich ein Hodentumor auftritt. Die Zellen der TIN sind im Gegensatz zu normalen Keimzellen PAS positiv und exprimieren die Plazentäre alkalische Phosphatase (PLAP), welche immunhistochemisch nachweisbar ist.
Bilder Typ
Histologie
Vergrösserung
200
Alter
36
Geschlecht
männlich
Datum
Ersteintrag: 06.05.2002
Update: 30.07.2010